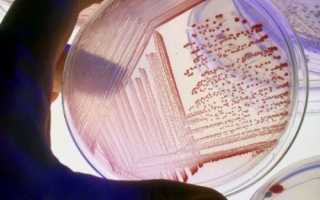

Мир вокруг нас просто кишит различными микроорганизмами. Они есть в воздухе, воде, почве, в нашем организме, они способны выживать даже в открытом космосе. Как же изучать и идентифицировать бактерии одного вида, как исследовать болезнетворные вирусы? Проблема в том, что микроорганизмов просто невероятно много, и все они разные. Но скопление (популяцию, колонию) бактерий одного и того же вида можно рассматривать как единый организм, что значительно упрощает определение и изучение микробов. Культура бактерий и есть такое искусственно выведенное с помощью посева скопление микроорганизмов.
Бактериальные культуры: чистые против смешанных
В микробиологии культурой бактерий называют популяцию микроорганизмов, растущую на питательной среде, которая используется в научных и медицинских целях. Различают:
- Чистые культуры. Микроорганизмы одного и того же вида, выращенные в искусственной среде in vitro («в пробирке») и являющиеся потомками одной бактериальной клетки. Своего рода изолированное скопление микроорганизмов, выведенное с помощью посева на питательных средах.
- Смешанные культуры. Сообщество бактерий разных видов, первоначально взятое из естественных источников (воздуха, воды, почвы) и культивированное (выращенное) в лабораторных условиях.
Чистая культура используется:
- в научных исследованиях;
- при диагностике инфекционных заболеваний;
- как исходный материал для производства вакцин, ферментов, антибиотиков, витаминов, гормонов и др.;
- в промышленном производстве (молочнокислые закваски, пивные и обычные дрожжи и т.д.).
Смешанная культура дает определение о поведении микробов «в естественной среде». То есть ученые получают возможность проследить за взаимодействием бактерий различного вида, появлением новых свойств, присущих микроорганизмам, только в «сожительстве» с другими видами. В отличие от математических законов в случае со смешанной культурой ее свойства не являются суммой свойств микробов, входящих в нее. Напротив, свойства такой субстанции могут сильно отличаться от характеристик составляющих ее микроорганизмов при их посеве и культивировании в изоляции (чистая культура).
Несмотря на то что выведение чистых культур стало мощным толчком в развитии микробиологии (и до сих пор является ее основным инструментом), смешанные культуры дают более полную картину окружающего мира, так как в природе скопления бактерий одного и того же вида обязательно контактируют с различными микроорганизмами, находящимися по соседству. Особую важность определение смешанной культуры приобретает в медицине, при исследовании взаимодействия различных инфекций с микрофлорой организма.
То есть определение заболевания основано на выведении чистых культур, а для полного изучения болезни в развитии необходимо исследовать смешанные культуры.
Врачи отмечают, что бактериальная культура представляет собой метод, позволяющий изолировать и размножать микроорганизмы в контролируемых условиях. Этот процесс важен для диагностики инфекционных заболеваний, разработки антибиотиков и изучения микробиоты. Специалисты подчеркивают, что “воспитание” бактерий требует строгого соблюдения стерильности и точности, чтобы избежать загрязнения и получить достоверные результаты. Врачам важно понимать, что каждая культура может вести себя по-разному в зависимости от условий, в которых она находится. Это знание помогает в выборе правильного лечения и профилактических мер. Кроме того, исследование бактериальных культур открывает новые горизонты в области микробиологии и медицины, позволяя находить инновационные решения для борьбы с инфекциями.

Выделение чистых культур
Как уже было сказано, чистая культура – многочисленное потомство одной-единственной клетки. Возникает вопрос: как же изолировать эту самую клетку? Ведь в образце, взятом для лабораторного анализа, находится огромное множество бактерий, причем необязательно одного и того же вида.
Для выведения чистой культуры существует несколько различных методов:
- Метод Луи Пастера (французский химик, один из основоположников микробиологии). Суть метода в последовательном разведении изучаемого образца в жидкости (в пробирке) до получения единичной клетки в заданном объеме. Этот метод интересен скорее в историческом, чем в практическом плане.
- Метод Роберта Коха (немецкий микробиолог). При этом способе исследования материал разводят в агар-агаре (при t⁰ 48-50), который затем разливают по чашкам Петри и дают застыть. Для посева (разлива) используют несколько последних разведенных образцов, где количество клеток значительно меньше. В дальнейшем это облегчает определение в глубине агар-агара и перенос колоний (скопление микробов, выросшее из единичной клетки) на другие питательные среды для непосредственного выведения чистой культуры.
- Метод Дригальского (немецкий исследователь). Пожалуй, самый распространенный вариант исследования. Метод состоит в том, что материал для анализа разводят в пробирке физраствором или бульоном, затем единственную каплю из пробирки переносят в чашку Петри (делают посев) и распределяют шпателем. Затем, не меняя и не стерилизуя шпатель, делают посевы поочередно в двух и более чашках. В последнем посеве на шпателе остается минимальное количество бактерий. Появляется высокая вероятность, что единичная клетка будет изолирована и на питательной среде разрастется в колонию бактерий одного вида.
Кроме этих, есть еще несколько специальных методов, применяемых для микроорганизмов, гибнущих на открытом воздухе или проводимых с помощью современной высокоточной техники.
Выделенные культуры бактерий одного и того же вида тщательно консервируют (высушивают, изолируют от атмосферы, подвергают заморозке и т. д.) и хранят в соответствии с инструкциями.
Коварная кишечная палочка
Наглядным примером использования бактериальных культур в медицине может стать кишечная палочка. С одной стороны, микроорганизмы группы кишечной палочки постоянно присутствуют в организме человека и животных, т.е. являются частью нормальной микрофлоры кишечника. С другой стороны, некоторые штаммы могут не только представлять опасность для здоровья, но и привести к смертельному исходу у людей с ослабленным иммунитетом (старики, маленькие дети).
Безвредные штаммы кишечной палочки, обитающие в организме хозяина, синтезируют необходимые витамины и «сражаются» с патогенными бактериями, попадающими в кишечник, отбирая у них пищу и жизненное пространство. Однако та же кишечная палочка отвечает за развитие:
- тяжелых пищевых отравлений;
- диареи;
- перитонита (при попадании в брюшную полость через разрыв в кишечнике);
- бактериального простатита;
- менингита у новорожденных и т.д.
Важной задачей является определение типа кишечной палочки и количества этих бактерий в организме человека. Для этого берутся анализы мочи, кала, мазок из влагалища, гноя, рвотных масс. Затем проводят выделение чистой культуры бактерий. Определить патогенность (опасность для здоровья) колонии микроорганизмов по внешнему виду достаточно сложно, ведь в нормальной микрофлоре тоже присутствует кишечная палочка. Поэтому изучают не только морфологию (форму и строение), но и биохимические свойства (процесс жизнедеятельности, влияние на окружающую среду). Затем полученные результаты сравнивают с имеющимися данными о «поведении» патогенных бактерий и назначают лечение.
Кроме того, микробиология научилась использовать свойства кишечной палочки для определения загрязнения окружающей среды. Дело в том, что кишечная палочка выводится из организма человека и животных вместе с фекальными массами. В случае попадания стоков в водоемы есть риск появления патогенных бактерий в обычной водопроводной воде, что может привести к серьезным эпидемиям.
Чтобы избежать подобного сценария, санитарно-эпидемиологическая служба регулярно берет образцы для лабораторных анализов. Именно кишечная палочка служит надежным индикатором чистоты воды. От того, какое количество бактерий одного вида будет найдено в образце, зависит показатель чистоты. Более того, анализируя полученные результаты можно даже определить источник загрязнения, то есть выяснить, кто является «поставщиком» бактерий: человек или животные.
Бактериальная культура — это не просто набор микроорганизмов, а целый мир, который можно изучать и контролировать. Люди, увлеченные микробиологией, часто делятся своими впечатлениями о процессе создания и воспитания «ручных» бактерий. Они отмечают, что это требует терпения и аккуратности, ведь каждая культура уникальна и требует индивидуального подхода. Многие исследователи говорят о том, как важно поддерживать оптимальные условия для роста: температура, pH и питательные среды играют ключевую роль.
Некоторые энтузиасты даже сравнивают работу с бактериями с искусством, где каждое вмешательство может привести к неожиданным результатам. В то же время, это занятие открывает двери к новым открытиям в медицине и экологии. Обсуждая свои успехи и неудачи, люди подчеркивают, что работа с бактериальными культурами — это не только наука, но и увлекательное хобби, которое может привести к значимым научным достижениям.

Бактериальные культуры в промышленности
Применение бактериальных культур в промышленности можно рассмотреть на примере молочнокислых бактерий. Представители одного и того же вида встречаются в организме человека и животных, на растениях, в молоке и молочнокислых продуктах. Они принимают участие в сбраживании молока, квашении капусты, силосовании кормов и даже в изготовлении заменителя плазмы крови.
Понятно, что в промышленных масштабах нельзя пускать процесс брожения, за который отвечают молочнокислые бактерии, на самотек. Следовательно, нужны значительные объемы бактерий одного и того же вида, чтобы получившийся в результате продукт всегда имел строго определенные свойства.
Возникает вопрос: как же вырастить требуемый объем молочнокислых бактерий (закваску)? Для этого понадобится питательная среда и собственно культура молочнокислых микроорганизмов, т.е. колония бактерий одного и того же вида, полученная в лабораторных условиях.
В промышленности используют так называемую периодическую систему культивирования молочнокислых бактерий, т.е. в питательную среду вносят определенное количество микроорганизмов, после чего больше не вмешиваются в процесс их размножения. Во время развития биомасса проходит несколько стадий (периодов). Сначала бактерии активно размножаются, затем количество пищи в питательной среде естественным образом уменьшается и микроорганизмы приостанавливают рост, а некоторые начинают отмирать.
Следовательно, периодическая система поддерживает рост колоний молочнокислых бактерий в течение определенного времени, после которого размножение прекращается и начинается отмирание клеток. В определенный период времени число живых бактерий становится равно количеству отмерших – наступает своеобразное равновесие. Именно в этот момент и приступают к сбору «урожая» молочнокислых бактерий, которые затем используют для приготовления наших любимых сыров, йогуртов, кефира, сметаны и других вкусных и полезных продуктов.
Казалось бы, какое отношение могут иметь выращенные в лаборатории бактерии к нашей повседневной жизни, но на практике микробиология настолько тесно вошла в наш обиход, что трудно даже представить, как можно обойтись без продуктов и технологий, созданных учеными-микробиологами.
Вопрос-ответ

Что такое культура микроорганизмов?
Культура микроорганизмов, популяции микроорганизмов (бактерии, археи, микроскопические грибы и водоросли, простейшие), выращенных на поверхности или в толще питательной среды, которая содержит все необходимые для их роста и развития вещества.
Что такое бактериальная культура в пищевых продуктах?
Бактериальные пищевые культуры отвечают за аромат, вкус и текстуру сыров и кисломолочных продуктов, таких как йогурты, айран, дук, скир или имер. Они способствуют формированию вкуса и цвета таких ферментированных продуктов, как салями, пепперони и вяленая ветчина.
Как называется культура микроорганизмов, выращенная из одного организма?
Штамм (от нем. Stamm, дословно — «ствол, род») — чистая культура бактерий, грибов и иных микроорганизмов, а также вирусов и прионов, выделенная из определённого источника и идентифицированная по тестам современной классификации.
Советы
СОВЕТ №1
Перед началом работы с бактериальными культурами обязательно ознакомьтесь с основами микробиологии. Понимание структуры и функций микроорганизмов поможет вам лучше контролировать их рост и поведение.
СОВЕТ №2
Используйте стерильные инструменты и среды для культивирования бактерий. Это поможет избежать загрязнения и обеспечит чистоту ваших экспериментов, что критически важно для получения надежных результатов.
СОВЕТ №3
Регулярно отслеживайте условия роста ваших культур, такие как температура, pH и уровень кислорода. Оптимизация этих параметров может значительно улучшить результаты и ускорить рост микроорганизмов.
СОВЕТ №4
Не забывайте о безопасности! Работая с бактериальными культурами, всегда используйте защитные средства, такие как перчатки и маски, и следуйте протоколам лабораторной безопасности, чтобы избежать возможных инфекций.